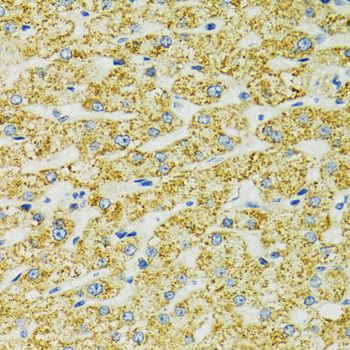

Filters
Clonality
Type
Reactivity
Gene Name
Isotype
Host
Application
Clone
164 results for " Heat Shock Protein" - showing 100-150
HSPA9, Polyclonal Antibody (Cat# AAA10628)
Hsc70, Polyclonal Antibody (Cat# AAA29879)
HSPB7, Polyclonal Antibody (Cat# AAA27732)
Hsp90 alpha, Monoclonal Antibody (Cat# AAA30033)
HSPA1B, Monoclonal Antibody (Cat# AAA26378)
HSPA1B, Monoclonal Antibody (Cat# AAA26643)
HSP105alpha, Monoclonal Antibody (Cat# AAA11727)
Hsp27, Monoclonal Antibody (Cat# AAA30243)
Hsp90, Monoclonal Antibody (Cat# AAA17786)
Hsp70/Hsc70, Monoclonal Antibody (Cat# AAA17784)
HSPA1B, Monoclonal Antibody (Cat# AAA25979)
Hsp70/Hsc70, Monoclonal Antibody (Cat# AAA17782)
HBP1, Polyclonal Antibody (Cat# AAA31326)
Hsp70/Hsc70, Monoclonal Antibody (Cat# AAA17791)
Hsp90, Monoclonal Antibody (Cat# AAA17794)
Hsp70/Hsc70, Monoclonal Antibody (Cat# AAA17793)
HSPA1B, Monoclonal Antibody (Cat# AAA26245)
HSP27/HSPB1, Polyclonal Antibody (Cat# AAA28328)
HSPB1, Monoclonal Antibody (Cat# AAA24539)
HSPB1, Monoclonal Antibody (Cat# AAA24834)
Hsp70/Hsc70, Monoclonal Antibody (Cat# AAA17795)
Heat Shock Protein 27, Polyclonal Antibody (Cat# AAA14726)
Purified by protein A and peptide affinity chromatography.
Hsp90, Monoclonal Antibody (Cat# AAA17788)
HSPB1, Monoclonal Antibody (Cat# AAA24243)
Hsp90 beta, Monoclonal Antibody (Cat# AAA30032)
HSPB1, Monoclonal Antibody (Cat# AAA25425)
Hsp90, Polyclonal Antibody (Cat# AAA11604)
Hsp70/Hsc70, Monoclonal Antibody (Cat# AAA17780)
Hsp90, Monoclonal Antibody (Cat# AAA17787)
HSPA8, Polyclonal Antibody (Cat# AAA23533)
BAG3, Polyclonal Antibody (Cat# AAA31421)
Predicted Reactivity: Pig (100%), Bovine (100%), Horse (100%), Sheep (100%), Rabbit (100%), Dog (100%)